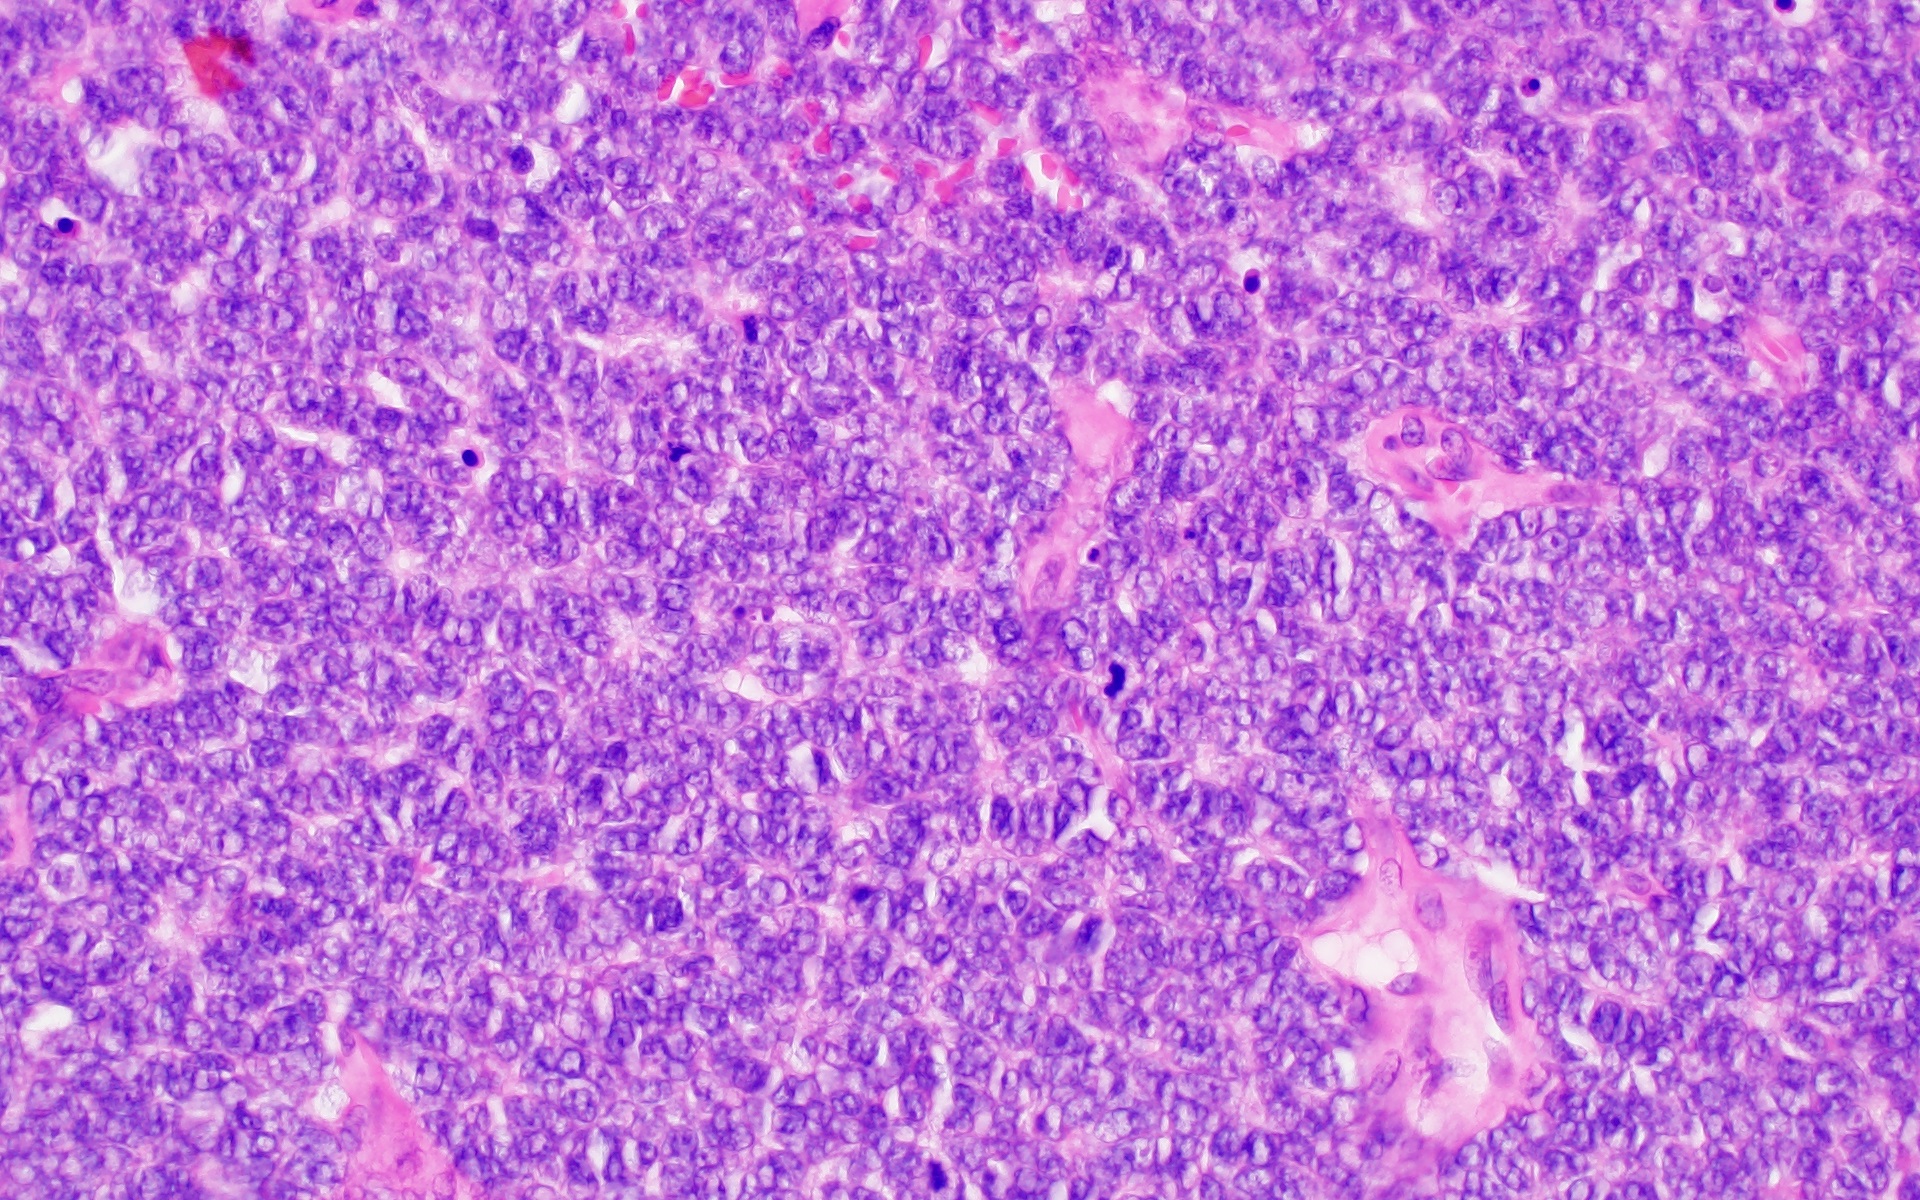

|
Case of the Month: March 2026
Title: 5-year-old with headache and vomiting Author: Jared T. Ahrendsen, MD, PhD Institution: Northwestern University Feinberg School of Medicine Clinical History: A 5-year-old child presents with acutely worsening headache, vomiting, and weakness. The child has no prior medical or family history. Radiology: Magnetic resonance imaging (MRI) demonstrates a large, irregular, variably enhancing mass involving the left frontal lobe with significant mass effect and probable dural involvement. Computed tomography (CT) of the chest, abdomen, and pelvis is negative for extracranial disease. Representative Histology / IHC:
Histology from the resection reveals sheets of monomorphic tumor cells with high nuclear to cytoplasmic ratio, clumpy chromatin, frequent apoptotic bodies, and numerous mitotic figures. In other areas, the tumor shows necrosis and infiltration of the dura.
By immunohistochemistry, the tumor cells are diffusely positive for CD99 (membranous) and Nkx2.2 (nuclear). Tumor cells show retained nuclear expression of INI1, BRG1, and H3K27me3. The tumor cells are negative for GFAP, Olig2, synaptophysin, BCOR, desmin, and myogenin. Questions for Viewers: 1) Based on the histomorphology, what is the differential diagnosis for this lesion? 2) What immunohistochemical stains would help with the differential diagnosis? Based on the immunohistochemical staining results, how would you refine your differential diagnosis? 3) What is the likely molecular alteration found in this lesion? |